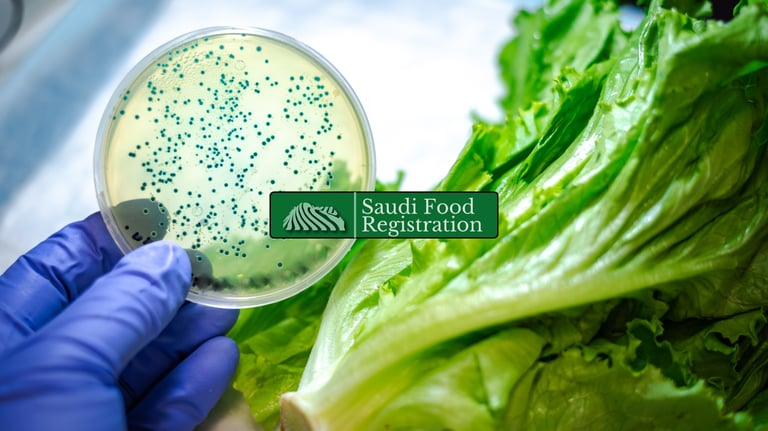
SFDA recall plan investigation showing lab contamination testing on fresh lettuce in Saudi Arabia

SFDA Recall Plan in Saudi Arabia: Requirements & Readiness
SFDA recall plan requirements in Saudi Arabia: traceability, notification, retrieval, disposal, and reporting—built to withstand audits and recalls.
2/19/20263 min read

SFDA Recall Plan Requirements in Saudi Arabia
Reviewed by: Saudi Food Registration Regulatory Team – Food Compliance & SFDA Advisory
An SFDA recall plan is not a theoretical compliance document. It is a legally expected risk-management mechanism that protects consumers, shields your registration status, and preserves market access in Saudi Arabia.
Regulators do not evaluate companies based on whether problems occur — they evaluate how quickly and professionally companies respond when they do.
This guide explains what SFDA expects, how recalls are triggered, what a defensible recall framework looks like, and how to build a system that withstands inspection, audit, and real-world activation.
What a Food Recall Means Under SFDA Oversight
A recall is the structured removal of a food product from distribution when a safety, labeling, or compliance risk is identified after market release.
Under SFDA supervision, recalls may be initiated due to:
Microbiological contamination (e.g., Salmonella, Listeria, E. coli)
Undeclared allergens
Misleading or non-compliant labeling
Incorrect shelf-life declarations
Foreign body contamination
Counterfeit or unauthorized imports
International regulatory alerts affecting imported goods
Recalls are not limited to contamination events. Documentation errors and labeling violations can trigger enforcement action just as quickly.
Is an SFDA Recall Plan Mandatory?
Yes — operationally and legally.
While the recall plan is not always submitted during initial product registration, SFDA expects every registered product to be backed by an internal recall system that can be activated immediately.
During audits, post-market surveillance, or incident investigations, companies must demonstrate:
Written recall procedures
Defined team responsibilities
Traceability capability
Communication protocols
Corrective action documentation
Absence of a structured recall system is treated as a compliance failure.
Why Recall Preparedness Is a Core Compliance Requirement
SFDA’s regulatory model emphasizes post-market control. Registration approval does not eliminate regulatory exposure — it begins continuous oversight.
A compliant recall framework ensures:
Rapid containment of unsafe batches
Controlled public communication
Protection of consumer health
Minimization of commercial disruption
Demonstrable regulatory cooperation
Companies that delay response or provide incomplete data during recall events often face suspension, shipment holds, or intensified inspections.
The Structural Components of a Compliant Recall System
An effective recall plan is built on five pillars.
1. Full Traceability Capability
Traceability is the foundation of recall effectiveness. Your system must allow immediate identification of:
Batch or lot numbers
Production dates
Raw material sources
Supplier details
Distribution channels
Import documentation (if applicable)
If you cannot trace one step backward and one step forward, your recall system is structurally weak.
2. Clearly Defined Recall Team
A compliant structure typically includes:
Regulatory lead responsible for SFDA communication
Quality assurance authority
Operations representative
Legal advisor
Communications contact for public notifications
Roles must be documented — not assumed.
3. Formal Notification Protocol
Upon identifying a risk, companies are expected to notify SFDA without delay. The notification must include:
Nature of the hazard
Affected batch numbers
Quantity distributed
Distribution locations
Initial containment actions
SFDA may require periodic progress updates until closure.
4. Product Retrieval and Disposal Controls
Returned goods must be:
Quarantined immediately
Segregated from saleable stock
Documented
Transported securely
Destroyed through approved facilities
Destruction records must be retained as evidence.
5. Root Cause and Corrective Action
Closing a recall without a root cause analysis invites repeat violations.
SFDA expects documentation explaining:
What failed
Why it failed
How recurrence will be prevented
This is often the most scrutinized part of recall reporting.
Common Weak Points in Recall Systems
Enforcement actions often arise from:
Incomplete distribution records
Delayed regulator notification
Poor batch coding practices
Weak supplier verification
Informal internal communication
Lack of recall simulations
The absence of rehearsal significantly increases compliance risk.
Should Companies Conduct Recall Drills?
While not always mandatory, recall simulations are strongly recommended.
A drill evaluates:
How quickly batches can be traced
Whether team roles function effectively
Communication speed
Documentation completeness
Companies that rehearse recalls respond significantly faster during real events.
Imported Products and Recall Liability
Imported products are equally subject to SFDA recall enforcement.
Brand owners, local agents, and importers share responsibility. Regulatory clarity must exist regarding:
Who notifies SFDA
Who retrieves goods
Who handles public communication
Who funds disposal and corrective action
Ambiguity in contractual responsibilities can delay recall execution, and regulators do not accept internal disputes as justification.
Consequences of Recall Mismanagement
Failure to manage recalls properly may result in:
Suspension or cancellation of product registration
Border shipment blocks
Administrative fines
Mandatory audits
Increased inspection frequency
Reputational damage affecting retail relationships
The financial exposure of recall failure often exceeds the cost of prevention.
How Often Should Recall Plans Be Reviewed?
A defensible system requires review:
At least annually
After supplier changes
After manufacturer changes
Following formulation updates
After regulatory updates
After any real recall event
Recall plans must evolve with operational reality.
Recall Readiness Is a Business Protection Strategy
An SFDA recall plan is not simply regulatory compliance — it is a corporate risk control instrument.
Companies that integrate recall readiness into broader compliance systems — including traceability, labeling control, supplier qualification, and change management, experience fewer enforcement escalations and shorter disruption windows.
Regulatory preparedness signals operational maturity.
Related Topics You Might Find Helpful
Learn how crisis management helps control product recalls
Discover how post-market surveillance identifies safety issues
See how facility registration improves product traceability
Facing unexpected registration delays? This guide explains how to avoid SFDA approval slowdowns in 2025.
Concerned that your product name might already exist in the Saudi market? Don’t miss our latest guide on handling trademark conflicts during SFDA registration
Final Perspective
In Saudi Arabia’s regulatory environment, the question is not whether recalls happen — it is whether your organization can manage one without regulatory escalation.
A structured, documented, and tested recall framework protects consumers, protects your brand, and protects your registration status.
If you need a professional review of your recall system or support building a compliant structure aligned with SFDA expectations, contact us or use the chatbot for a structured compliance assessment.